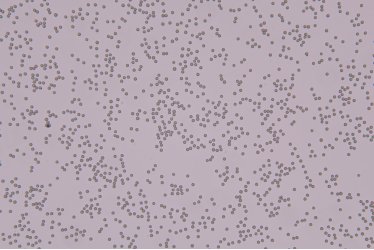

鴻蒙標準物質正式推出國內首套完整滿足《JJF 1665-2017流式細胞儀校準規范》的線性校準熒光微球標準物質。本系列產品包含PE/FITC雙通道標準物質,創新性提供分裝式(6瓶/套)與混合式(單瓶6mL) 兩種規格,徹底解決實驗室校準效率與數據可比性難題。
一核心技術突破
1.全規范指標覆蓋
嚴格對標《JJF 1665-2017流式細胞儀校準規范》校準需求:
? 線性校準:驗證熒光信號強度與濃度的線性關系。
? 光路校直:優化激光束與檢測器對齊,提高分辨率。
? 靈敏性與穩定性測試:監控儀器長期性能波動。
? 質量控制:用于實驗室內部質控、檢測方法評價及操作人員技能考核。
2.革命性混合微球設計
? 單瓶集成"空白微球+5種熒光微球"混合液
二新品亮點:雙通道全場景適配
1、PE 通道專用標準物質
① BW 036111-036116(6 瓶 / 套):含1瓶空白微球+5種梯度熒光強度微球,滿足多濃度線性校準需求。
②BW 036117(單瓶 6mL 混合液):空白與5種熒光微球預混,即開即用,適合快速校準。
應用場景:主要用于流式細胞儀PE通道的線性校準、分辨力、光路校直、檢出限。
2、 FITC 通道專用標準物質
①BW 036101-036106(6 瓶 / 套):1 瓶空白微球 + 5 種梯度熒光強度微球,精準匹配 FITC 通道校準要求。②BW 036107(單瓶 6mL 混合液):預混型設計,簡化操作流程,提升校準效率。
應用場景:主要用于流式細胞儀FITC通道的線性校準、分辨力、光路校直、檢出限。
三數據可靠性驗證,質控無憂


熒光微球標準物質(PE)線性校準示例圖(圖1)

熒光微球標準物質(PE)的FSC圖與SSC圖(圖2)

熒光微球標準物質(PE)的PE圖與FITC圖(圖3)

熒光微球標準物質(FITC)線性校準示例圖(圖4)

熒光微球標準物質(FITC)的FSC圖與SSC圖(圖5)

熒光微球標準物質(FITC)的PE圖與FITC圖(圖6)
四可視化質量驗證
PE 微球(488 激發 / 575 發射):熒光信號均一且穩定,可溯源至NIST的MESF值,可直接量化PE通道的檢測限和線性范圍。(圖 1)

FITC 微球(488 激發 / 525 發射):熒光信號均一且穩定,可溯源至NIST的MESF值,可直接量化FITC通道的檢測限和線性范圍。(圖 2)

聚苯乙烯空白微球:微球球形度高度均一、粒徑分布窄且具有穩定性。(圖 3)
五即刻體驗,開啟精準檢測新征程




















